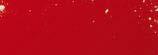

-33% 1,19 1,79 -25% 2,59 3,49 2,19* 12,99* ES -50%
3,69
2,49 EC HHZ · 23/33 14.08. lidl.bg/q u d a l
1,84
-21% 1,95
1,29


-21%





2,49
1,99


3,89







lidl.bg/qudal





PE GR
3,19
g
2 16.08.











































-42% 0,12 0,21 11,99* 6,49* 7,99* ПРЯСНО МЕСО ОПАКОВАНO ЗАLIDL СЕРТИФИЦИРАНО ОТ SGS 3,99* ПРЯСНО МЕСО ОПАКОВАНO ЗАLIDL СЕРТИФИЦИРАНО ОТ SGS + 0,99 1,99 -50% 7205 7220 0 05566995 95 lidl.bg/qudal 3






























1 kg 6,95* OLYMPUS MAGGI -28% 1,99 2,79 -27%
4,79
5,99* 4,99*
*
* 4 4 6 STAROBRNO TUBORG EFES MALT
3,49
0,85*
9,99
1,39
4
BACARDI BREEZER
7,49 11,99






























BELLAROM NESCAFÉ DOLCE GUSTO 16 16 5



























































-25% 7,45 9,99 -25% 5,35 7,15 -25% 5,19 6,99
6 -25% lidl.bg/qudal
12,69* 18,99*






























































1 l 100 g 6,69* -25% 6,29 8,49 9, 99*
-20% 2,69 3,39 7
13,99* 15,29*
6,99*

5,99*
9,49*
11,99*











-30%








6,99 9,99

12
8






















+ GORDON’S 4,49 5,99
* 2,5 l
3,59 -50% -20% 0,79 0,99 9
14,99
1,79





























BELLINI -20% 5,19 6,49 12,99* 6,49* 5,99* -20% 7,99 9,99 -20% 10,59 13,29 -26% 1,69 2,29 10















































+ + + + + -50% 1,89 3,79 -50% 2,24 4,49 -50% 3,99 7,99 -50% 3,24 6,49 -50% 3,24 6,49 -50% 11
-33% 1,19 1,79

lidl.bg/qudal -33%
12
-50% 1,84









3,69
















-50%
lidl.bg/qudal
13
5,98





7,49
14,99









6,49*


6,39







4,69*

* 1
*
*
* 14
4,79*
1,5





































19,99*


18,99*












7,49*

3,99*
3,99*
1 15






















100 g 5,99* 100 g 9,98* 12,49* 4
* 5,49* 24 IT 11,99* ø 16
9,99
11,99*
















15,49*




9,49*
6 7 12,99*
1,5
2 kg
kg
8,99*
17
1,5 kg





























* 3
* 8 9,99* ДА СЕ КОНСУМИРА ОТГОВОРНО И УМЕРЕНО ОТ ЛИЦА НАД 18 ГОДИШНА ВЪЗРАСТ – 2,79*
* 18
4,99
4,98
3,89










































8
*
* 7,99* 8 7,49* 8 8 3,59*
* 8 19
5,99
4,99
5,99























50 ml
* 5 85 g
*
* 200 g 16,99* 1,2 kg 20
1,99
3,79
3,99





























12 70 g 5,19* 500 6,99* 2-пластова 12 100 g 4,75* 20 + 4 14,95* 10 + 2 11,90* 24 21




























1 1 5%--+ + 1 300 400 00 200 80
*
* 22
3,99
2,99
6,99








5,99











4,99















4,99*









*
1,29
6,49* -23% 0,99*
0,79*
*
* 23

















































* 10 – 12° C
*
* 6 30
*
* ДА СЕ КОНСУМИРА ОТГОВОРНО И УМЕРЕНО ОТ ЛИЦА НАД 18 ГОДИШНА ВЪЗРАСТ – -26%
* 2,69 24 HHZ · 23/33
3,49
6,49* 5,49
7,49
4,99
6,99
1,99
3,49*


10,99


















1,29*
2,99*

2,59






3,99*

25 HHZ · 23/33






























-1-1 PARKSIDE® 3 PARKSIDE® 3 PARKSIDE® 1 2 1 2 7 99* 3 111 99* PARKSIDE® 119 99* 84 99* 125 100 75 1 125 PARKSIDE® 8 99* 7 2 26



















-1 PARKSIDE® PARKSIDE® 1 2 PARKSIDE® 3 3 2 1 18 10 3 99*** 34 99* PARKSIDE® 9 99* 3 3 3 PARKSIDE® 3 79 99* PARKSIDE® 65 99* 69 99* PARKSIDE® 84 99* 69 99 27






















PARKSIDE® -¹ " ") PARKSIDE® 17,99* 14 3 79,99* PARKSIDE® -¹ 3 PARKSIDE® 5,99* mm ø mm ø mm ø 100 ø PARKSIDE® 3 64,99* ø ø ø ø 54,99* ! 28
3,99*** 5,99**




29
PARKSIDE®













PARKSIDE® PARKSIDE® 159,99* 79,99* 99,99* 3 PARKSIDE® 33 3 16 mm 30


















30 mm 60 mm PARKSIDE® 44,99* 44,99* 10,99* PARKSIDE® PARKSIDE® 4 bar 7,4 V/1800 mAh 9 W 3 IP 44 806 lm 30 000 h макс. 12 m 3 90 mm 69,99* 31




















1 2 Ø 41 x 3 cm ERNESTO® ROCKTRAIL ROCKTRAIL ROCKTRAIL GRILLMEISTER 44,99* 34,99* 9,99* 7,99* 470 ml НЕРЪЖДАЕМА СТОМАНА 80 x 51 x 54 cm 80 x 51 x 54 cm 110 max. kg 110 max. kg l 39,99* 32






























17,99* , 99* ! ESMARA® LIVERGY® ESMARA® 11,98* Точен размер 7,99* ESMARA® Точен размер Точен размер Точен размер , 99* ESMARA® Точен размер 33




































14.08. 15.08. 4,49 4,99 7,99 15 – 17° C 19 cm ø 6,5 cm ø 9,99* 7 cm ø 7,99* 14 cm ø 8,49* 19 cm ø 28,99* 16,5 cm ø 33,99* 13,99* 10,5 cm ø 6,99* 1,99 34






















3 AURIOL® AURIOL® SILVERCREST® 3 3 ® 7,99* 80 200 22,99* 1,5 m 34,99* 3 190 W 24,99* 29,99* 27,99* 100m 300 lm 3,2 W 350 lm 3,8 W 360 lm 4,3 W 25 000 h m 35






















SILVERCREST® KITCHEN TOOLS SILVERCREST® KITCHEN TOOLS SILVERCREST® KITCHEN TOOLS SILVERCREST® KITCHEN TOOLS 12,99* 59,99* 109,99* 149,99* 0,85 m 3 max. 300ml max. 150ml l ICE CRUSH Проверено Удобство при Проверен за вредни дълготрайна 1,5 m 5 НЕРЪЖДАЕМА СТОМАНА 27 x 42 x 30 cm 850 W 3 Проверено Удобство при Проверен за вредни дълготрайна 5 kg 60% 36 HHZ · 23/33




























НЕРЪЖДАЕМА СТОМАНА ERNESTO® 8,99* 1,99* 15,99* 10,99* 10,99* ERNESTO® ERNESTO® 40° С 0° С 7,99* ERNESTO® 3 5 30 x 23 x 2 cm 4 11,99* ERNESTO® 1 25 x 8 x 20 cm 2 ERNESTO® SILVERCREST® KITCHEN TOOLS 300 160 37 HHZ · 23/33
































PLAYTIVE AURIOL® 115 ml 2
* 0,56 cm 8,5“ 12–18 cm 12,99* SILVERCREST®
* 5,49* 14,99* 10,99 14,99 60 ml 4 1 500 ml 38
9,99
7,99


























CRELANDO® 1 2 CRELANDO® CRELANDO® PLAYTIVE 1 2 3 4 12 12 ml 10 18 ml 8 PLAYTIVE 28 22 82 13,99* 19,99* 9,99* 4,99* 12,99* PLAYTIVE Safety www.tuv.com ID 0000076745 76 151 1 22,99* 190 g/m 60 90 g/m 100 1 2 1 2 3 2 4 2 1 2 39














































PEPPERTS® 12,98* 11,97* 11,96* Точен размер LUPILU® 9,98* Точен размер LUPILU® LUPILU® Точен размер PEPPERTS® Точен размер 8,96*** 12,96** Точен размер HHZ · 23/33
















































LUPILU®
*
* Точен размер 2 2 2 2 2 2 2 2 Точен размер HHZ · 23/33
12,99
9,99* 10,98






























PEPPERTS® 8,96 Точен размер HHZ · 23/33
0,99 1,99











43 HHZ · 23/33

























500 g 2,75 PL -20% 1,99 2,49 GR -50% 0,99 1,99 -20% 1,59 1,99 0,65 0,79 lidl.bg/qudal 44






















































-33% 0,79 1,19 -51% 0,18 0,37 5,99* ПРЯСНО МЕСО ОПАКОВАНOЗАLIDL 9,99* 6,49 8,49 5,99* . lidl.bg/qudal 45
-42% 1,09 1,89

















































-42% lidl.bg/qudal
46
-50% 1,74 3,49

























-50% lidl.bg/qudal
47



















































-27% 4,69 6,49 5,49* -21% 1,09 1,39 -20% 1,19 1,49 -40% 2,99 4,99 + 4,09 8,19 -50% 2 lidl.bg/qudal 48


































1,99* -25% 7,49 9,99 -36% 3,49 5,49 -27% 1,59 2,19 4,49 5,99 + 0,67 1,35 -50% 19,69* 49





































-42% 1,09 1,89 3 10,99* 5,89* ДА СЕ КОНСУМИРА ОТГОВОРНО И УМЕРЕНО ОТ ЛИЦА НАД 18 ГОДИШНА ВЪЗРАСТ –-50% 1,74 3,49 PARKSIDE® 199,99*** 224,99** 20.08. 6 5,99* 50 www.lidl.bg/kontakt www.lidl.bg lidl.bg/qudal






199,99*** 224,99** 20.08. 3 PARKSIDE® 19.08.




HHZ · 23/33
С Lidl Plus спестяваш не само в Lidl! Партньори

















































» » » » HHZ · 23/34









